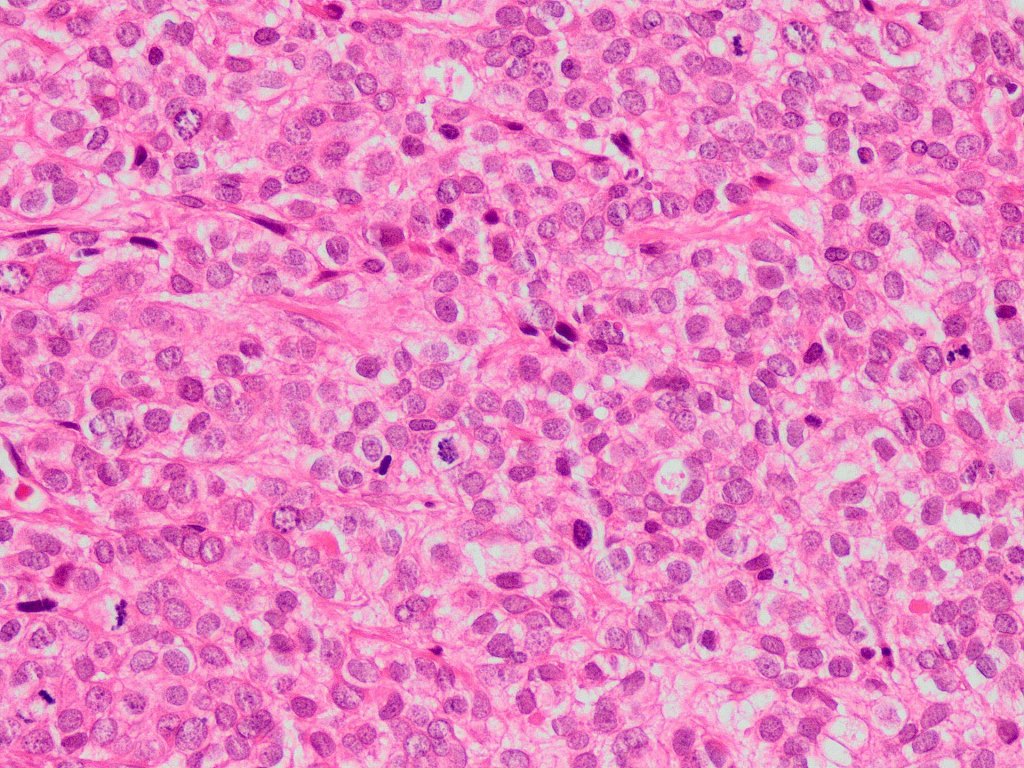
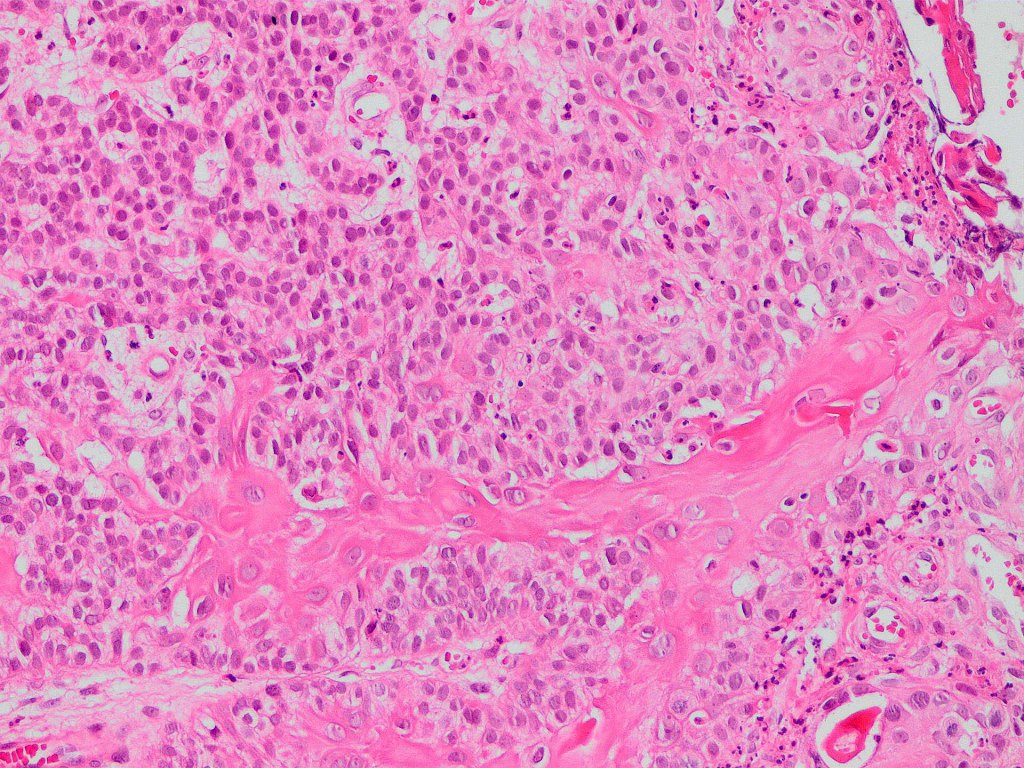
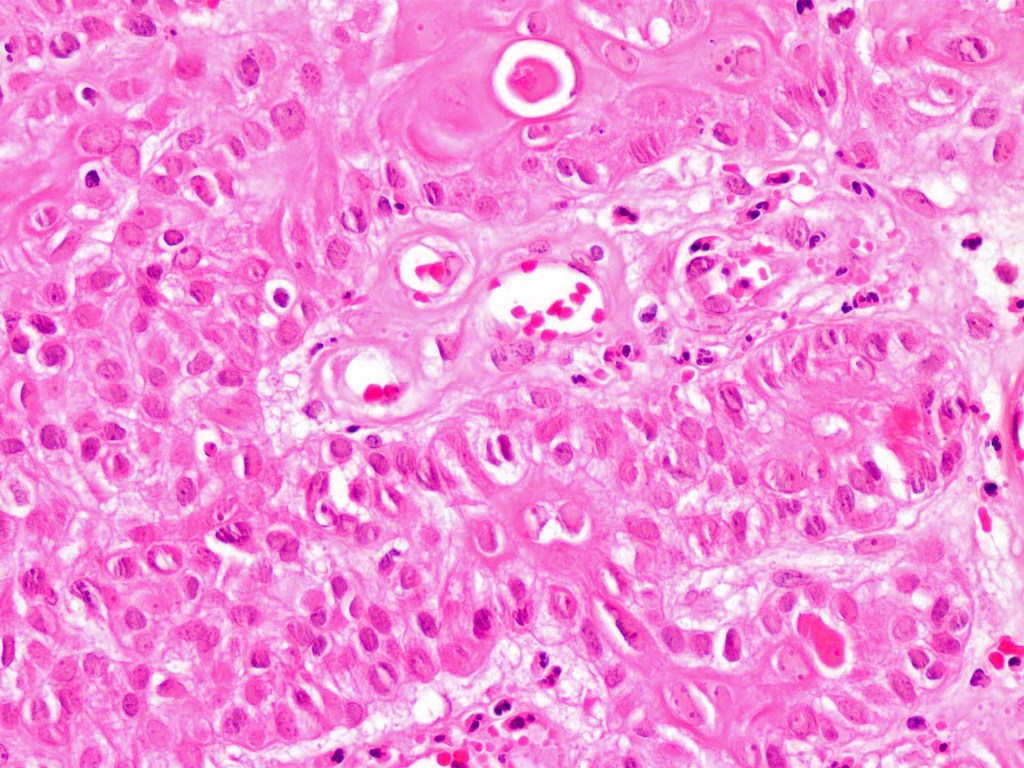
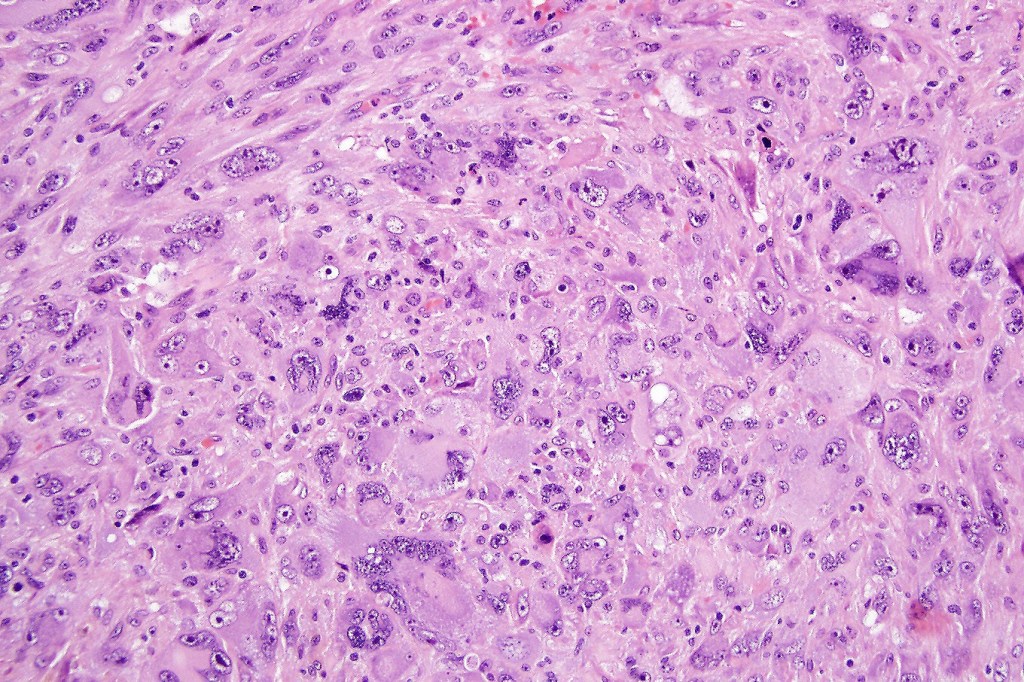
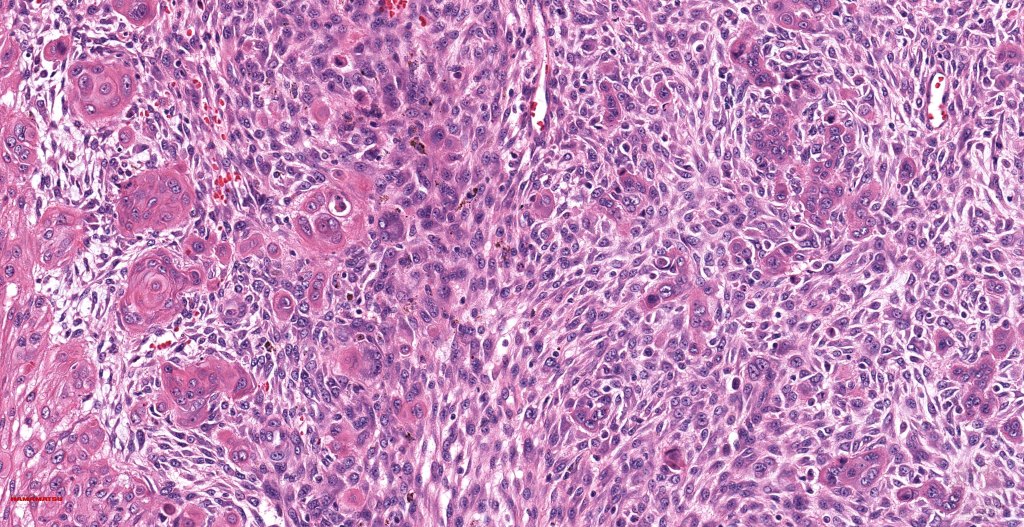
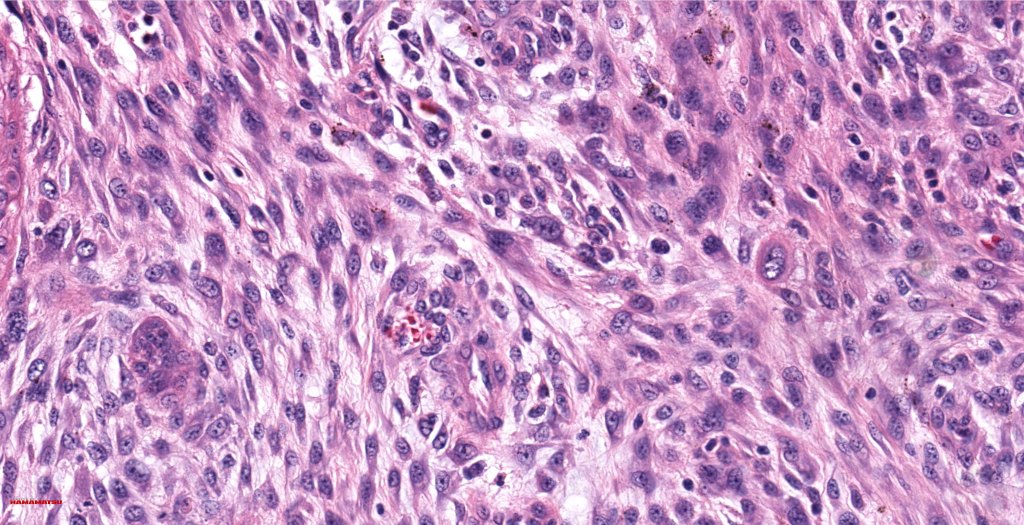

Clinical features
•Exceedingly rare variant
•Elderly patients
•M>>F
•Sun-damaged skin of head & neck
•Often rapidly growing, ulcerated, often large exophytic, nodular tumor
. 5-year survival-70%
Histological features
•Tp53, CDKN2A & PIK3CA mutations variable detected
•Biphasic tumor
•Possible epithelial to mesenchymal transition
•Overexpression of YAP may be at least in part responsible for this phenotype
•Admixture of squamous carcinoma & pleomorphic spindled cell, osteoid, chondroid, MFH-like +/- osteoclast-like giant cells & rarely, smooth muscle, skeletal muscle, myofibroblastic or angiosarcomatous elements
•Epithelial component AE1/AE3, CK5/6 & p63 +ve;
•Mesenchymal element variable CD10, CD68, CD99 & lineage specific markers +ve; scattered cells may show weak keratin expression

Differential diagnosis
If only the sarcomatous component is present in the biopsy specimen, it will only be when the lesion is fully excised that the correct diagnosis can be made. The main differential diagnosis is metastatic metaplastic squamous cell carcinoma (which can arise at a very wide variatey of sites). Clinicopathological correlation is often essential.
Leave a comment